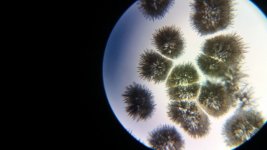
pic01+harmine-DHH+50-50.jpg

-
Members of the previous forum can retrieve their temporary password here, (login and check your PM).
You are using an out of date browser. It may not display this or other websites correctly.
You should upgrade or use an alternative browser.
You should upgrade or use an alternative browser.
Harmine, harmaline and THH from Syrian Rue. Verification and finetuning of the VDS-protocols
- Thread starter An1cca
- Start date
-
- Tags
- harmaline harmine syrian rue thh
Migrated topic.
Yes! The caterpillar (harmine/DHH 50/50) was succesfully converted to harmine/THH, separated with sodium bicarbonate and precipitated using ammonia AS WELL AS CARBONATE (=AMMONIA-FREE ROUTE!). Now I'm cleaning up the harmine fraction following VDS's protocol (ammonia-free route included). This guy deserves a statue made from recrystallized DHH
I'll post the details and pictures tomorrow...

I'll post the details and pictures tomorrow...
An1cca thanks for checking out on the AC yield effects and the sodbicarb/sodcarb separation technique for harmine/DHH. Your 75/79 % is very close to VDS's 76%.
Post #160, pic [2] looks like DHH no doubt, then pic [4] looks like harmine needles, but pic [3] looks like THH bolders? Never saw before harmine nor DHH form the round forms? Was there no error in the uploads?
* * *
CO2 in solution skewing the pH, yes VDS was saying so, maybe that is also the true origin of the brown-goo-spook we had when basing a reduction solution with sodbicarb then sodcarb?
Post #160, pic [2] looks like DHH no doubt, then pic [4] looks like harmine needles, but pic [3] looks like THH bolders? Never saw before harmine nor DHH form the round forms? Was there no error in the uploads?
* * *
CO2 in solution skewing the pH, yes VDS was saying so, maybe that is also the true origin of the brown-goo-spook we had when basing a reduction solution with sodbicarb then sodcarb?
Jees said:Post #160, pic [2] looks like DHH no doubt, then pic [4] looks like harmine needles, but pic [3] looks like THH bolders? Never saw before harmine nor DHH form the round forms? Was there no error in the uploads?
This is what harmine recrystallizes like when no glass covering plate is put over the recrystallizing drop on the microscopic slide. The needles from pic04 are a destroyed "radially clustered harmine-needle mothership" :surprised after placing a covering slide on top.
Jees said:CO2 in solution skewing the pH, yes VDS was saying so, maybe that is also the true origin of the brown-goo-spook we had when basing a reduction solution with sodbicarb then sodcarb?
There was no spook this time..:thumb_up:
Yes, not in 2.4 but eagerly waiting for the 2.7 , very curious for that one.An1cca said:...There was no spook this time..:thumb_up:
Got my zinc powder yesterday and Ive done my first reduction. Didnt turn out quite as expected though..
I started with 2g of mixed alks ( harmaline/ harmine) from a syrian rue extraction, mansked to remove quinazolines.
This was dissolved in 50ml 5% vinegar and 2.3g zinc powder added.
Left bubbling for 24 hours, remaining zinc filtered out. Clear yellow solution.
Added some 5-12% ammonia solution and milky precipitate formed, then redissolved. Decided to go for excess ammonia route and added approx 50 ml very quickly. Now the white precipitate stayed, but yellow/brown globules also formed and stuck to the sides of the container.
Im in the process of filtering the solution now but it looks like most of the solids are in the form of brown goo.
When I dried some of this goo, it hardened and could then be crushed to form a tan coloured powder. Maybe this is the thh/harmine freebase, together with plant oils or something? Maybe it all coagulated because I added the ammonia too quickly?
Ill try redissolving it in vinegar and precipitating again, or maybe perform a manske on it. Ill weigh it first if I can scrape it all out of the jar!
I started with 2g of mixed alks ( harmaline/ harmine) from a syrian rue extraction, mansked to remove quinazolines.
This was dissolved in 50ml 5% vinegar and 2.3g zinc powder added.
Left bubbling for 24 hours, remaining zinc filtered out. Clear yellow solution.
Added some 5-12% ammonia solution and milky precipitate formed, then redissolved. Decided to go for excess ammonia route and added approx 50 ml very quickly. Now the white precipitate stayed, but yellow/brown globules also formed and stuck to the sides of the container.
Im in the process of filtering the solution now but it looks like most of the solids are in the form of brown goo.
When I dried some of this goo, it hardened and could then be crushed to form a tan coloured powder. Maybe this is the thh/harmine freebase, together with plant oils or something? Maybe it all coagulated because I added the ammonia too quickly?
Ill try redissolving it in vinegar and precipitating again, or maybe perform a manske on it. Ill weigh it first if I can scrape it all out of the jar!
Ijahdan, very nice to hear that you're collaborating as well!:thumb_up: Instead of scraping, you can also add some 5% vinegar to the recipient and redissolve the sticky precipitate. I must say that the brown-goo-spook turned up quite unexpectedly. Ammonia hasn't done this for me nor for Jees. Hmmm, puzzling.:?
I'm currently investigating our yield problem. That is to say: why our yields are more like 50% instead of the 84% that Van Der Sypt gets out of his conversions. And if my scale confirms what I see with the naked eye, I might just have a clue as to why...and this might be helpful to explain your problem as well...more to come. First I'll post my succesfull confirmation of protocol 4 (experiment 2.7).
I'm currently investigating our yield problem. That is to say: why our yields are more like 50% instead of the 84% that Van Der Sypt gets out of his conversions. And if my scale confirms what I see with the naked eye, I might just have a clue as to why...and this might be helpful to explain your problem as well...more to come. First I'll post my succesfull confirmation of protocol 4 (experiment 2.7).
So after quite some experiments we went through searching for an ammonia-free route, I decided this time to stick to the protocol VDS used.
Therefore, I reacted 1024mg of harmine and 1042mg DHH in 66ml of vinegar 7% to which 2026mg Zn-powder was added. During the conversion process, I took some microscopic pictures. At the start, one can observe the caterpillar's family (pic01) as well as some birds flying by (pic02). After half an hour, the crystal-agglomerates begin to look like 'feathery flowers' (pic03-04). At 90 minutes, the feathers change into leafs (pic05). After many more hours, the crystal shapes become less uniform and one sees thorn-like bushes as well as flattened radial leafs (pic06-10). In the end however, the agglomerates get smaller, as we have already observed in the DHH(only) to THH conversion (pic11).
So after 22 hours, the zin was filtered off and to the clear orange-brown solution, 4g of NaHCO3 were added (pic12). Completely in line with Van Der Sypt's observations, the fifth gram of bicarbonate provoked clouding in the solution. Then an additional 75ml of water and 12g of bicarbonate were added. After letting the harmine and salts precipitate for 15 minutes, the solution was filtered (pic14) and the residue dried (2258mg). The filtrate however, started clouding again (as we have observed in the past when using bicarbonate). I let it settle and the precipitate seemed to be harmine (pic16). So I ran it through the filter again. And again. The third time, the filtrate stayed clear (pic17). The first times I ran it through the filter, the combined action of the filter and the vacuum that was applied caused much foaming and hence decomposition of the carbonic acid present. Only when the solution stopped foaming, the filtrate did not cloud anymore.
CONCLUSION: IN ALL EXPERIMENTS WHERE SODIUM (BI)CARBONATE IS APPLIED AND CARBONIC ACID IS FORMED, ONE MUST MAKE SURE THE DECOMPOSITION OF THE LATTER IS COMPLETE. IF NOT, THE pH OF THE SOLUTION WILL RISE ON STANDING/DECOMPOSING, AND ISOLATION AS WELL AS SEPARATION OF ALKALOIDS WILL BE INCOMPLETE.
I suspect VDS did not have this problem because he presumably used a stirrer of some sort (for accurate and continuous pH-reading). This would have caused the carbonic acid to decompose. I will not go into detail now, but continuous stirring and incremental basification may also contribute to higher yields, I will post on this experiment shortly.
Anyways, the 180ml of cear filtrate were divided and to the first 90ml, another 50ml of water were added and then 13g sodium carbonate in 150ml of water were dumped in. This resulted in THH 'snowing out' (pic18 ) . NO BROWN-GOO-SPOOK! The precipitate was filtered, washed with 2x20ml of sodium carbonate solution 1% and after drying yielded 222mg (only 44%!).
To the other 90ml, 50ml of water were added and then 30ml of ammonia 12% were dumped in. The precipitate was filtered, washed with 2x20ml ammonia 6% and upon drying yielded 240mg (47%).
Then for the harmine clean-up: the 2258mg of bicarbonate precipitation (including the refiltrations of clouded filtrate) were divided into a first fraction of 1122mg that was dissolved in 20ml of acetic acid 7% and 130ml of water. To this solution, 20ml of ammonia 12% were added at once and after standing for 15 minutes, the solution was filetered, the residue washed with 2x30ml of ammonia 6% and dried to give 478mg (yield 94%!). The residue has the typical looks and feel of 'netted' harmine-needles and appears to be very clean.
Then the remaining 1138mg were 'Mansked' by dissolving in 20ml of acetic acid 7% + 10ml of water. Then 30ml of sodium chloride (9g/30ml) were added. Immediately, the solution turned milky. After some hours of reorganisation into needle-clusters, the solution was filtered and washed 2x with 30ml of saturated NaCl-solution. The bright yellow residue was then dissolved in 150ml of water and a solution of 10g of sodium carbonate in 50ml of water was dumped in. After settling, filtration and washing with 3x20ml of sodium carbonate 1% solution, the residue was dried to yield 476mg (92%!) of the cleanest harmine I've ever seen (pic19). It is even slightly whiter than the ammonia-precipitate, possibly because of the extra Manske.
CONCLUSION: A COMPLETE AMMONIA-FREE ROUTE IS INDEED POSSIBLE. THH AS WELL AS HARMINE CAN BE SEPARATED AND RECOVERED USING SODIUM (BI)CARBONATE (and sodium chloride) ONLY.
The harmine is recovered with excellent yields and seems to have been purified by the reduction process. This seems to be an extra benefit of the combined HAR-DHH reduction. I slowly freebased some to give the result in pic208) .
It really looks like Van Der Sypt tuned the protocols to get around the brown-goo-spook :thumb_up: . The only thing that bothered me were the very low yields (less than 50%) compared to Van Der Sypt's (more than 80%):? . So then again, I tried to adhere more strictly to his protocols... (next post).
And for those Nexians who managed to follow me all the way here, there's a bonus (pic21): a Deep Dream interpretation of pic07. Since the crystal consists of harmine and THH only (caapi copy), I would call it 'The face of the Vine'.
Man, how I love the (microscopic) world of harmala's ....
....
Therefore, I reacted 1024mg of harmine and 1042mg DHH in 66ml of vinegar 7% to which 2026mg Zn-powder was added. During the conversion process, I took some microscopic pictures. At the start, one can observe the caterpillar's family (pic01) as well as some birds flying by (pic02). After half an hour, the crystal-agglomerates begin to look like 'feathery flowers' (pic03-04). At 90 minutes, the feathers change into leafs (pic05). After many more hours, the crystal shapes become less uniform and one sees thorn-like bushes as well as flattened radial leafs (pic06-10). In the end however, the agglomerates get smaller, as we have already observed in the DHH(only) to THH conversion (pic11).
So after 22 hours, the zin was filtered off and to the clear orange-brown solution, 4g of NaHCO3 were added (pic12). Completely in line with Van Der Sypt's observations, the fifth gram of bicarbonate provoked clouding in the solution. Then an additional 75ml of water and 12g of bicarbonate were added. After letting the harmine and salts precipitate for 15 minutes, the solution was filtered (pic14) and the residue dried (2258mg). The filtrate however, started clouding again (as we have observed in the past when using bicarbonate). I let it settle and the precipitate seemed to be harmine (pic16). So I ran it through the filter again. And again. The third time, the filtrate stayed clear (pic17). The first times I ran it through the filter, the combined action of the filter and the vacuum that was applied caused much foaming and hence decomposition of the carbonic acid present. Only when the solution stopped foaming, the filtrate did not cloud anymore.
CONCLUSION: IN ALL EXPERIMENTS WHERE SODIUM (BI)CARBONATE IS APPLIED AND CARBONIC ACID IS FORMED, ONE MUST MAKE SURE THE DECOMPOSITION OF THE LATTER IS COMPLETE. IF NOT, THE pH OF THE SOLUTION WILL RISE ON STANDING/DECOMPOSING, AND ISOLATION AS WELL AS SEPARATION OF ALKALOIDS WILL BE INCOMPLETE.
I suspect VDS did not have this problem because he presumably used a stirrer of some sort (for accurate and continuous pH-reading). This would have caused the carbonic acid to decompose. I will not go into detail now, but continuous stirring and incremental basification may also contribute to higher yields, I will post on this experiment shortly.
Anyways, the 180ml of cear filtrate were divided and to the first 90ml, another 50ml of water were added and then 13g sodium carbonate in 150ml of water were dumped in. This resulted in THH 'snowing out' (pic18 ) . NO BROWN-GOO-SPOOK! The precipitate was filtered, washed with 2x20ml of sodium carbonate solution 1% and after drying yielded 222mg (only 44%!).
To the other 90ml, 50ml of water were added and then 30ml of ammonia 12% were dumped in. The precipitate was filtered, washed with 2x20ml ammonia 6% and upon drying yielded 240mg (47%).
Then for the harmine clean-up: the 2258mg of bicarbonate precipitation (including the refiltrations of clouded filtrate) were divided into a first fraction of 1122mg that was dissolved in 20ml of acetic acid 7% and 130ml of water. To this solution, 20ml of ammonia 12% were added at once and after standing for 15 minutes, the solution was filetered, the residue washed with 2x30ml of ammonia 6% and dried to give 478mg (yield 94%!). The residue has the typical looks and feel of 'netted' harmine-needles and appears to be very clean.
Then the remaining 1138mg were 'Mansked' by dissolving in 20ml of acetic acid 7% + 10ml of water. Then 30ml of sodium chloride (9g/30ml) were added. Immediately, the solution turned milky. After some hours of reorganisation into needle-clusters, the solution was filtered and washed 2x with 30ml of saturated NaCl-solution. The bright yellow residue was then dissolved in 150ml of water and a solution of 10g of sodium carbonate in 50ml of water was dumped in. After settling, filtration and washing with 3x20ml of sodium carbonate 1% solution, the residue was dried to yield 476mg (92%!) of the cleanest harmine I've ever seen (pic19). It is even slightly whiter than the ammonia-precipitate, possibly because of the extra Manske.
CONCLUSION: A COMPLETE AMMONIA-FREE ROUTE IS INDEED POSSIBLE. THH AS WELL AS HARMINE CAN BE SEPARATED AND RECOVERED USING SODIUM (BI)CARBONATE (and sodium chloride) ONLY.
The harmine is recovered with excellent yields and seems to have been purified by the reduction process. This seems to be an extra benefit of the combined HAR-DHH reduction. I slowly freebased some to give the result in pic208) .
It really looks like Van Der Sypt tuned the protocols to get around the brown-goo-spook :thumb_up: . The only thing that bothered me were the very low yields (less than 50%) compared to Van Der Sypt's (more than 80%):? . So then again, I tried to adhere more strictly to his protocols... (next post).
And for those Nexians who managed to follow me all the way here, there's a bonus (pic21): a Deep Dream interpretation of pic07. Since the crystal consists of harmine and THH only (caapi copy), I would call it 'The face of the Vine'.
Man, how I love the (microscopic) world of harmala's
 ....
....Attachments
-
 pic13+HAR-THH+%2B+5g+NaHCO3.jpg43.7 KB · Views: 3
pic13+HAR-THH+%2B+5g+NaHCO3.jpg43.7 KB · Views: 3 -
 pic14+filtering+off+NaHCO3+fraction.jpg42.5 KB · Views: 3
pic14+filtering+off+NaHCO3+fraction.jpg42.5 KB · Views: 3 -
 pic15+clouding+of+filtrate.jpg47.1 KB · Views: 2
pic15+clouding+of+filtrate.jpg47.1 KB · Views: 2 -
 pic16+harmine+precipitation+from+degassed+filtrate.jpg41.6 KB · Views: 2
pic16+harmine+precipitation+from+degassed+filtrate.jpg41.6 KB · Views: 2 -
 pic17+clear+THH-only+filtrate.jpg37.6 KB · Views: 3
pic17+clear+THH-only+filtrate.jpg37.6 KB · Views: 3 -
 pic18+Snowing-out+THH+with+sodium+carbonate.jpg29.3 KB · Views: 3
pic18+Snowing-out+THH+with+sodium+carbonate.jpg29.3 KB · Views: 3 -
 pic19+Clean+harmine+from+post-Manske+sodium+carbonate+precipitation.jpg43.2 KB · Views: 3
pic19+Clean+harmine+from+post-Manske+sodium+carbonate+precipitation.jpg43.2 KB · Views: 3 -
 pic20+Harmine+freebased.jpg37 KB · Views: 6
pic20+Harmine+freebased.jpg37 KB · Views: 6 -
 pic21+The+face+of+the+Vine.jpg291.7 KB · Views: 5
pic21+The+face+of+the+Vine.jpg291.7 KB · Views: 5 -
 pic12+HAR-THH+%2B+4g+NaHCO3.jpg49.6 KB · Views: 6
pic12+HAR-THH+%2B+4g+NaHCO3.jpg49.6 KB · Views: 6 -
 pic11+HAR-DHH+to+HAR-THH+22+hours+(3).jpg47.6 KB · Views: 2
pic11+HAR-DHH+to+HAR-THH+22+hours+(3).jpg47.6 KB · Views: 2 -
 pic10+HAR-DHH+to+HAR-THH+22+hours+(2).jpg37.6 KB · Views: 2
pic10+HAR-DHH+to+HAR-THH+22+hours+(2).jpg37.6 KB · Views: 2 -
pic01+harmine-DHH+50-50.jpg43.1 KB · Views: 2
pic01+harmine-DHH+50-50.jpg43.1 KB · Views: 2 -
 pic02+harmine-DHH+50-50+(2).jpg26.2 KB · Views: 2
pic02+harmine-DHH+50-50+(2).jpg26.2 KB · Views: 2 -
 pic03+HAR-DHH+to+HAR-THH+30min.jpg26.2 KB · Views: 2
pic03+HAR-DHH+to+HAR-THH+30min.jpg26.2 KB · Views: 2 -
 pic04+HAR-DHH+to+HAR-THH+30min+(2).jpg31.6 KB · Views: 2
pic04+HAR-DHH+to+HAR-THH+30min+(2).jpg31.6 KB · Views: 2 -
 pic05+HAR-DHH+to+HAR-THH+90min.jpg32.1 KB · Views: 2
pic05+HAR-DHH+to+HAR-THH+90min.jpg32.1 KB · Views: 2 -
 pic06+HAR-DHH+to+HAR-THH+13hours.jpg23 KB · Views: 3
pic06+HAR-DHH+to+HAR-THH+13hours.jpg23 KB · Views: 3 -
 pic07+HAR-DHH+to+HAR-THH+20hours.jpg27.1 KB · Views: 4
pic07+HAR-DHH+to+HAR-THH+20hours.jpg27.1 KB · Views: 4 -
 pic08+HAR-DHH+to+HAR-THH+20hours+(2).jpg36 KB · Views: 3
pic08+HAR-DHH+to+HAR-THH+20hours+(2).jpg36 KB · Views: 3 -
 pic09+HAR-DHH+to+HAR-THH+22+hours.jpg25.4 KB · Views: 3
pic09+HAR-DHH+to+HAR-THH+22+hours.jpg25.4 KB · Views: 3
Nice pictures. I'll try this procedure for my next 2g mixed alks (got about 10g left).
The brown goo, meanwhile, has dried and become less sticky. It crumbles into light brown powder when scraped. Only got about 1g of (presumably) harmine/thh out of 2g harmine/harmaline/impurities before reduction. Really want to end up with nice white crystals one day.
The brown goo, meanwhile, has dried and become less sticky. It crumbles into light brown powder when scraped. Only got about 1g of (presumably) harmine/thh out of 2g harmine/harmaline/impurities before reduction. Really want to end up with nice white crystals one day.
Ijahdan, from what I have learned, it is a good idea to stick to VDS's protocols as close as possible (the experimental protocols I mean under the section 'Methods' ). His protocols seem optimized for yield as well.
Adding your base slowly (dropwise) under continuous stirring (mechanical if available), will substantially increase yields (mine rose with 50%!). This might also prevent the spook from entering your recipient. Good luck!
Adding your base slowly (dropwise) under continuous stirring (mechanical if available), will substantially increase yields (mine rose with 50%!). This might also prevent the spook from entering your recipient. Good luck!
downwardsfromzero
Boundary condition
Nice to see what you can acheive using a wine preserving pump. That's at the top of the shopping list now.
Your observations with the use of sodium bicarbonate highlight the importance of following experimental methods to the letter: did Van der Sypt use a stirrer for the reduction or not? This would surely affect the yield as well.
It's possible that the spook is an oxidation artifact: wouldn't enhanced outgassing of CO2 provide a slight inert blanket, preventing the absorption of as much oxygen? Bubbling nitrogen or preferably argon through the mixture might be worth a shot.
My final thought was that zinc salts are sometimes used as paint driers, thus they could also catalyse the oxidative coupling of harmala alkaloids to form reddish gunk.
Your observations with the use of sodium bicarbonate highlight the importance of following experimental methods to the letter: did Van der Sypt use a stirrer for the reduction or not? This would surely affect the yield as well.
It's possible that the spook is an oxidation artifact: wouldn't enhanced outgassing of CO2 provide a slight inert blanket, preventing the absorption of as much oxygen? Bubbling nitrogen or preferably argon through the mixture might be worth a shot.
My final thought was that zinc salts are sometimes used as paint driers, thus they could also catalyse the oxidative coupling of harmala alkaloids to form reddish gunk.
ijahdan I hope you get it sorted, brown goo with ammonia frowns my eye brows.
An1cca great works there. Have to study more of that post.
I've tried to provoke goo or sticky results on a harmala free vessel:
- first just vinegar + sodbicarb so there was a load of CO2 for sure, then sodcarb and all I got was a misty end result.
- second experiment: solving ZnOH/ZnCO3 in vinegar and did same from there, first sodbicarb so there was a load of CO2, then sodcarb. Everything went normal, flocculent formed and later started to disappear, all as expected, no goo.
This suggests that the sticky goo has to do with the presence of harmalas in the mix.
Coming around the goo-spook, it's in the details it seems, like the CO2 suggestions, like suddenly VDS does things like "add 75 ml of water" or 150 ml water at certain points in the procedure and not specifying why, but it all seems to matter.
My works have been stalled a bit due life, but a reduced deems n-oxide liquid was based with ammonia only, and the absence of flocculent Zn-effects were much apreciated.
BTW Ordered a microscope, something like VDS used.
Could barely stop myself going for this :lol: :

An1cca great works there. Have to study more of that post.
I've tried to provoke goo or sticky results on a harmala free vessel:
- first just vinegar + sodbicarb so there was a load of CO2 for sure, then sodcarb and all I got was a misty end result.
- second experiment: solving ZnOH/ZnCO3 in vinegar and did same from there, first sodbicarb so there was a load of CO2, then sodcarb. Everything went normal, flocculent formed and later started to disappear, all as expected, no goo.
This suggests that the sticky goo has to do with the presence of harmalas in the mix.
Coming around the goo-spook, it's in the details it seems, like the CO2 suggestions, like suddenly VDS does things like "add 75 ml of water" or 150 ml water at certain points in the procedure and not specifying why, but it all seems to matter.
My works have been stalled a bit due life, but a reduced deems n-oxide liquid was based with ammonia only, and the absence of flocculent Zn-effects were much apreciated.
BTW Ordered a microscope, something like VDS used.
Could barely stop myself going for this :lol: :

We had done these tests before, but this time I made super sure there was a ton of CO2 in bubbles and in dissolved form. Just to see if spook was due CO2 solely. Not so.
But CO2 could be, of course, a major factor when harmalas are part of the vessel. You took good care of eliminating CO2 in the last tests. But then you also took good care about the concentrations that were suggested by VDS, so it could also be that, or the combination of concentrations + CO2. We might get to the bottom of this later.
Ammonia gets more tempting along the way
Another thing that wonders me: I could easily live with a low yield of THH, but then where's the unreacted DHH? We put in like 1 gr of DHH, and see back 0.5 gr of THH, but where is the other half gram gone :?:
Oh and BTW, the girl came with that TITAN scope if you're interested :twisted:
But CO2 could be, of course, a major factor when harmalas are part of the vessel. You took good care of eliminating CO2 in the last tests. But then you also took good care about the concentrations that were suggested by VDS, so it could also be that, or the combination of concentrations + CO2. We might get to the bottom of this later.
Ammonia gets more tempting along the way

Another thing that wonders me: I could easily live with a low yield of THH, but then where's the unreacted DHH? We put in like 1 gr of DHH, and see back 0.5 gr of THH, but where is the other half gram gone :?:
Oh and BTW, the girl came with that TITAN scope if you're interested :twisted:
Jees said:Another thing that wonders me: I could easily live with a low yield of THH, but then where's the unreacted DHH? We put in like 1 gr of DHH, and see back 0.5 gr of THH, but where is the other half gram gone :?:
I don't think there's any unreacted DHH left as microscopic examination of the mother liquor and redissolving-reprecipitation of the residue give identical results where no DHH can be recognized. Also, Endlessness et al. confirmed this by LC/MS.
The main challenge is to get all the THH out of the mother liquor. I managed to get a yield of about 75% now by slow basification and continuous stirring. Downwardsfromzero also expected these higher yields from stirring. Can you explain why? Are more free THH-molecules 'caught' and integrated into larger clusters as they swirl by in the solution...?
Will post experimental details this evening. I made a stirrer based upon this concept: How to Make a Cheap, Portable Magnetic Stirrer It works like a charm!
OK, so I'll give some details about my highest-yielding DHH conversion yet: 956mg of DHH was dissolved in 50ml of vinegar 7% and 2g of zinc were added (following VDS-experiment 2.5). This mixture was stirred mechanically for 10 minutes with intervals of 30 minutes inbetween (my primitive potentiometer-voltage divider-circuit substantially heated the potentiometer and its handle, ouch!)
. After 6 hours of this stirring, a drop of solution was recrystallized with ammonia for a microscopic confirmation of complete reduction (pic01). Following VDS's protocol, I left the muxture stand for an additional 3 hours after which it was filtered. After adding wash- and rinsing water and a little extra, the volume of filtrate was brought to 100ml.
Then ammonia 12% was added dropwise under continuous stirring. Each time a drop hit the surface, a ghost of THH/Zn-salt appeared and was then quickly twisted away again by the stirring. I didn't measure pH this time, but after 5,5ml of ammonia, a mist appeared in the solution. Slow addition of ammonia was continued and then, at 12,5ml, the mist vanished again! That's right, before any other precipitation had started:thumb_up: ! Not much later, at 13ml, another mist appeard again that at 13,5ml really fell out as thick precipitate. Then, the addition of ammonia was continued up to 20ml.
The solution was stirred for 10 more minutes after which it was left to stand for an additional half hour. Then it was filtered and the residue was washed in the Büchner funnel with 2x20ml of ammonia 6%. After drying, this yielded 732mg=77% of what should be THH. It was a little more colored than the previous precipitates. LC/MS analysis of this sample amongst others is planned. Then we'll know if its purity is comparable to the lower yield precipitates.
CONCLUSION: STIRRING AND/OR SLOW BASIFICATION HAVE SUBSTANTIAL IMPACT ON YIELD.
What I like as well was the observation that the first mist disappeared before the THH-mist would form. Intuitively, this makes me think the alkaloid will not be contaminated at all, especially not after an extra ammonia-wash. We'll see when the samples have been analyzed...(pic02)
. After 6 hours of this stirring, a drop of solution was recrystallized with ammonia for a microscopic confirmation of complete reduction (pic01). Following VDS's protocol, I left the muxture stand for an additional 3 hours after which it was filtered. After adding wash- and rinsing water and a little extra, the volume of filtrate was brought to 100ml.
Then ammonia 12% was added dropwise under continuous stirring. Each time a drop hit the surface, a ghost of THH/Zn-salt appeared and was then quickly twisted away again by the stirring. I didn't measure pH this time, but after 5,5ml of ammonia, a mist appeared in the solution. Slow addition of ammonia was continued and then, at 12,5ml, the mist vanished again! That's right, before any other precipitation had started:thumb_up: ! Not much later, at 13ml, another mist appeard again that at 13,5ml really fell out as thick precipitate. Then, the addition of ammonia was continued up to 20ml.
The solution was stirred for 10 more minutes after which it was left to stand for an additional half hour. Then it was filtered and the residue was washed in the Büchner funnel with 2x20ml of ammonia 6%. After drying, this yielded 732mg=77% of what should be THH. It was a little more colored than the previous precipitates. LC/MS analysis of this sample amongst others is planned. Then we'll know if its purity is comparable to the lower yield precipitates.
CONCLUSION: STIRRING AND/OR SLOW BASIFICATION HAVE SUBSTANTIAL IMPACT ON YIELD.
What I like as well was the observation that the first mist disappeared before the THH-mist would form. Intuitively, this makes me think the alkaloid will not be contaminated at all, especially not after an extra ammonia-wash. We'll see when the samples have been analyzed...(pic02)
Attachments
Ok, so now I ran out of crude alkaloids and even of isolated DHH. I have enough harmala's in the freezer now to inhibit an MAO-saurus:lol: . Practical research is gonna stop for me now, but I'm planning on compiling the information we gathered already into things that people would call 'teks'  . It looks as if they are gonna be very analogous to the experiments of VDS with some helpful additions from our own research. I'll put them in the OP under an 'EDIT'-heading. This way, people can just get what they need while others continue checking and finetuning. I'm afraid that interested people are perhaps overwhelmed by now by all this practical chemistry and no more realize that these are actually easy procedures. Would this be helpful? Or should this condensed information be made availabe in another part of the Nexus...? It would also be nice to integrate pictures into the text. Is this possible? There is an 'insert image' button on top of the post-editor, but I have no idea how to insert a picture between the tags that appear :? ..?
. It looks as if they are gonna be very analogous to the experiments of VDS with some helpful additions from our own research. I'll put them in the OP under an 'EDIT'-heading. This way, people can just get what they need while others continue checking and finetuning. I'm afraid that interested people are perhaps overwhelmed by now by all this practical chemistry and no more realize that these are actually easy procedures. Would this be helpful? Or should this condensed information be made availabe in another part of the Nexus...? It would also be nice to integrate pictures into the text. Is this possible? There is an 'insert image' button on top of the post-editor, but I have no idea how to insert a picture between the tags that appear :? ..?
 . It looks as if they are gonna be very analogous to the experiments of VDS with some helpful additions from our own research. I'll put them in the OP under an 'EDIT'-heading. This way, people can just get what they need while others continue checking and finetuning. I'm afraid that interested people are perhaps overwhelmed by now by all this practical chemistry and no more realize that these are actually easy procedures. Would this be helpful? Or should this condensed information be made availabe in another part of the Nexus...? It would also be nice to integrate pictures into the text. Is this possible? There is an 'insert image' button on top of the post-editor, but I have no idea how to insert a picture between the tags that appear :? ..?
. It looks as if they are gonna be very analogous to the experiments of VDS with some helpful additions from our own research. I'll put them in the OP under an 'EDIT'-heading. This way, people can just get what they need while others continue checking and finetuning. I'm afraid that interested people are perhaps overwhelmed by now by all this practical chemistry and no more realize that these are actually easy procedures. Would this be helpful? Or should this condensed information be made availabe in another part of the Nexus...? It would also be nice to integrate pictures into the text. Is this possible? There is an 'insert image' button on top of the post-editor, but I have no idea how to insert a picture between the tags that appear :? ..?downwardsfromzero
Boundary condition
Feel free to knock it together in the shape of a wiki entryAn1cca said:Or should this condensed information be made availabe in another part of the Nexus...?

We'd all love to see what you've come up with, I'm sure!I made a stirrer based upon this concept: http://www.instructables...table-Magnetic-Stirrer/ It works like a charm!
+1 for sumarizing into simple proceedure instructions. 
Pics are def welcome. You can either make it in a PDF, or post the text in a post, upload pics to the nexus and use the code like
to have them show up with the text. Or write a wiki (but I remember I had some problem editing the wiki recently, you might want to try it out first before working on a long article there).
When the LC-MS results are in, they can be added to the post
Thanks a lot guys for all of this work, excellent stuff!

Pics are def welcome. You can either make it in a PDF, or post the text in a post, upload pics to the nexus and use the code like
Code:
[img]www.address.com/example.jpg[/img]When the LC-MS results are in, they can be added to the post

Thanks a lot guys for all of this work, excellent stuff!
Similar threads
- Replies
- 4
- Views
- 510
- Replies
- 1
- Views
- 410
- Replies
- 2
- Views
- 272
- Replies
- 0
- Views
- 222
- Replies
- 3
- Views
- 807



